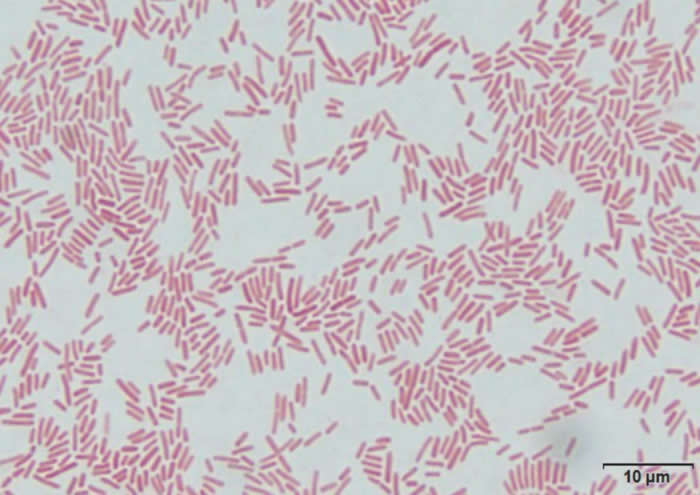
һ����ϸ�����ܻ�ٳ���������Ⱦ������Һ���Σ�ջ���

一种新细菌可能会促成新生儿感染后脑中液体的危险积聚
一种新细菌可能会促成新生儿感染后脑中液体的危险积聚(Credit: J.N. Paulson et al., Science Translational Medicine (2020) / Steven Schiff created the composite and calculated locations on map. Graphics from the paper, from Schiff personal photos, and map adapted and based on OCHA/ReliefWeb (UN Office for the Coordination of Humanitarian Affairs) and used as permitted by the agency.)
(蜘蛛网eeook.com报道)据EurekAlert!:据对乌干达100名婴儿所做的分析,研究人员发现了一种新细菌,它可能会促成新生儿感染后脑中液体的危险积聚。尽管需要更多的研究来确定因果关系,但他们的结果标志着在确定感染后脑积水的微生物病源方面取得了长足进步;感染后脑积水是全世界儿童进行神经外科手术的最常见原因。
对该细菌的确认还可为该病更有效的预防和制定治疗策略进行铺垫;该疾病仍然是发展中国家的一个重大的医卫负担。每年估计有40万感染后脑积水病例,该病通常发生于出生后不久正从血液感染中恢复的婴儿。尽管这种病从理论上讲是可预防的,但科学家们仍不确定哪些微生物引起了局部流行地区的感染后脑积水。因此,临床医生缺乏进行预防的工具,并靠耗资不菲的神经外科手术来防止患儿的脑损伤和死亡。
为了寻找来自细菌、病毒和真菌的DNA,Joseph Paulson和同事对两组乌干达婴儿的血液和脑脊髓液样本进行了测序:64名婴儿罹患感染后脑积水,另外36名婴儿的脑积水则与感染无关。由此产生的基因画像显示,在感染后的婴儿组中存在着一种新的占主导地位的类芽孢杆菌属菌株(它的存在与较严重的脑损伤相关),但该菌株在非感染性脑积水婴儿中则不存在。该研究团队还指出,类芽孢杆菌经常与巨细胞病毒感染同时发生,而巨细胞病毒是一种在儿童和成人中都常见的病毒。
Paulson等人告诫说,他们的研究具有地理范畴的局限性,且不能解释类芽孢杆菌与巨细胞病毒之间的确切关系。不过,他们说,他们的泛微生物分析法可能会帮助发现另外的世界上其它地区感染后脑积水的微生物病原。